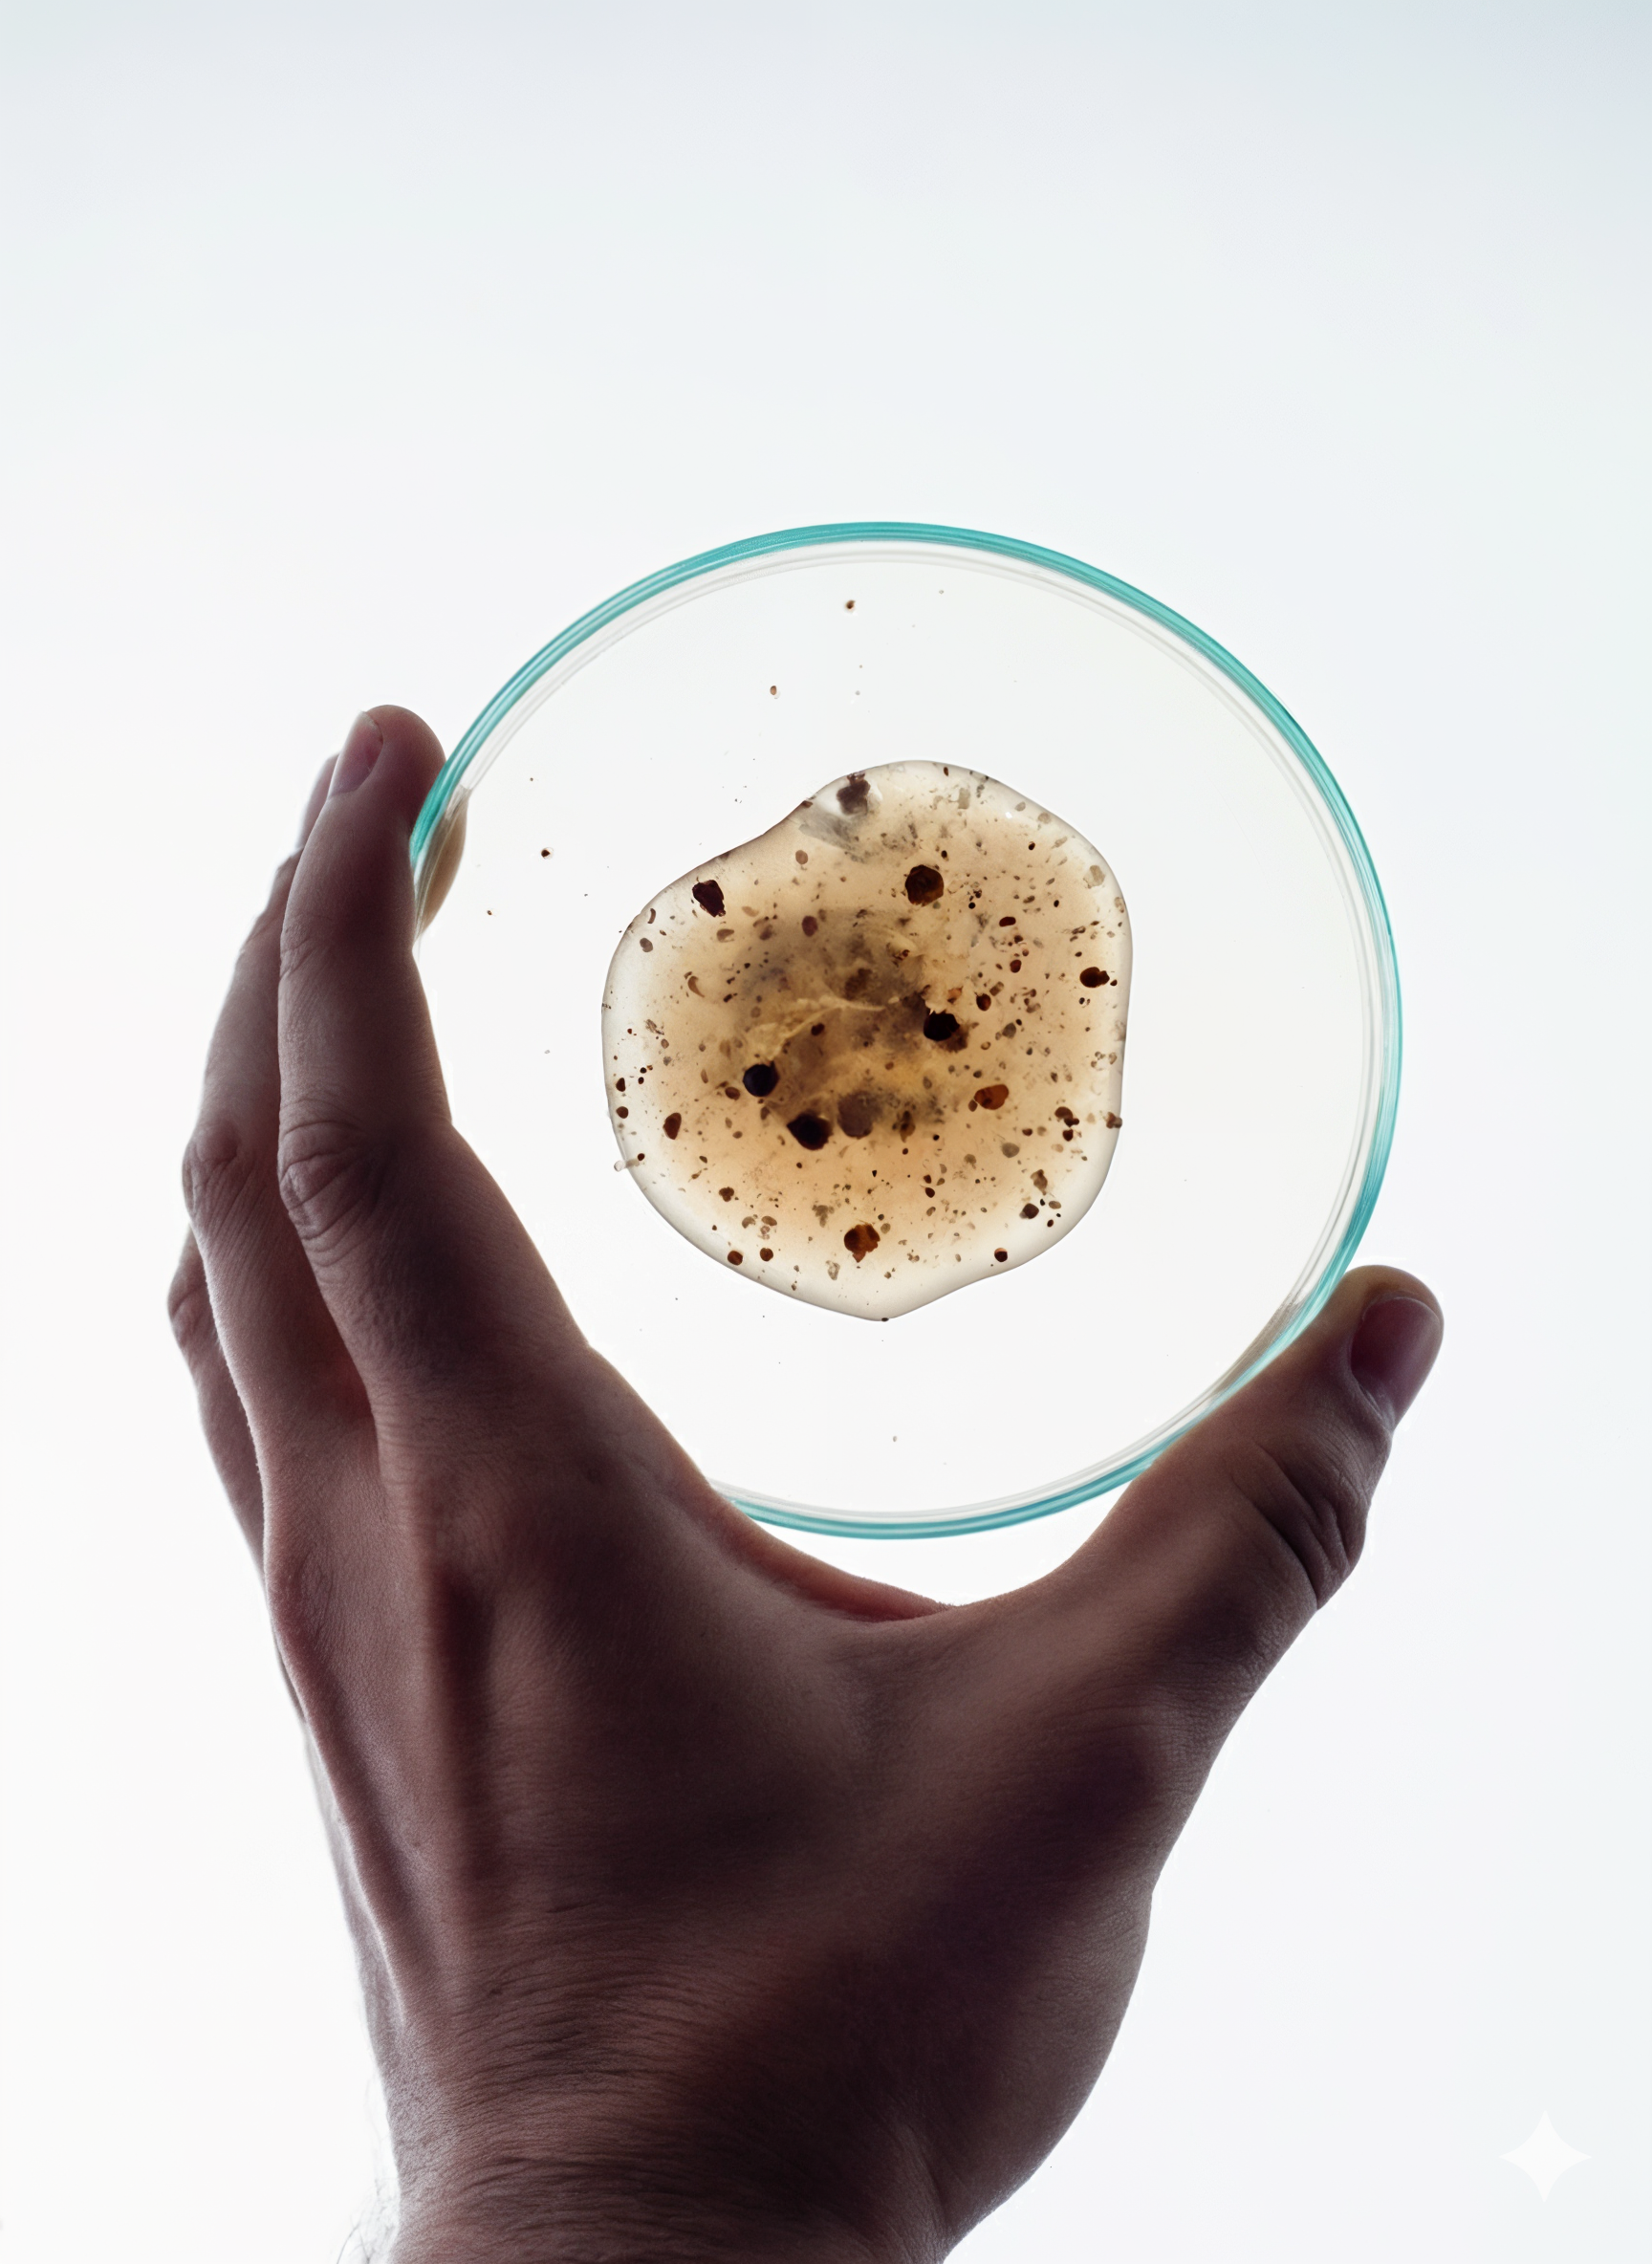

ohne spülung & vorbereitung
Sauber & Spontan
Quillt auf das 15× Volumen auf
Die Formel
Jede Kapsel enthält Psyllium, Aminosäuren und unseren geschützten CoreFiber Complex® – eine abgestimmte Kombination aus Quell- und Bindestoffen.

Die Aktivierung
Im Körper kommt die Kapsel in Kontakt mit Flüssigkeit und quilt auf das bis zu 15-fache Volumen auf. Dabei bildet sie ein festes Gel mit hoher Bindungsfähigkeit.

Der Prozess
Dieses Gel bewegt sich sanft durch den Körper, nimmt überschüssige Flüssigkeit auf und verbindet lose Nahrungsreste zu einer kompakten Masse – sodass nichts zurückbleibt.
Das Ergebnis
Deine Toilettengänge werden vollständiger und rückstandsfreier – ohne Spülung, ohne zusätzlichen Aufwand. Für ein sauberes Gefühl und echte Spontanität.


Erhältlich in deiner Nähe
Apotheke finden
Unsere Inhaltsstoffe
Präzise Formeln, höchste Reinheit – jeder Inhaltsstoff in unseren LAB46-Boostern erfüllt eine klare Funktion.

-
01
3580 mg
Gewonnen aus den Samen der Pflanze Plantago ovata. Kann das bis zu 15-fache seines Eigenvolumens an Wasser aufnehmen und quillt dabei zu einer wässrigen Masse auf.


-
02
310 mg
Unser eigens entwickelter Komplex wird aus sieben Pflanzenextrakten milligrammgenau hergestellt. Er stabilisiert das aufgequollene Psyllium zu einem festen Gel und verleiht ihm eine hohe Bindungsfähigkeit – wie ein natürlicher Klebstoff.


-
03
70 mg
Ein löslicher Ballaststoff aus der Konjakwurzel. Er nimmt Wasser auf, quillt stark und bildet eine zähflüssige, gelartige Substanz – die natürliche Basis für Stabilität und Bindung.


-
04
46 mg
L-Glutamin ist eine semi-essentielle Aminosäure und gehört zu den bedeutendsten Aminosäuren im menschlichen Stoffwechsel. Sie ist ein zentraler Baustein vieler Proteine.


-
05
56 mg
Gewonnen aus den Samen der Guarbohne. Bekannt für seine klebrige, verdickende Konsistenz, die bereits in geringen Mengen Flüssigkeit bindet und zähflüssig macht.


Präzise Formeln, höchste Reinheit – jeder Inhaltsstoff in unseren LAB46-Boostern erfüllt eine klare Funktion.
Gewonnen aus den Samen der Pflanze Plantago ovata. Kann das bis zu 15-fache seines Eigenvolumens an Wasser aufnehmen und quillt dabei zu einer wässrigen Masse auf.
Unser eigens entwickelter Komplex wird aus sieben Pflanzenextrakten milligrammgenau hergestellt. Er stabilisiert das aufgequollene Psyllium zu einem festen Gel und verleiht ihm eine hohe Bindungsfähigkeit – wie ein natürlicher Klebstoff.
Ein löslicher Ballaststoff aus der Konjakwurzel. Er nimmt Wasser auf, quillt stark und bildet eine zähflüssige, gelartige Substanz – die natürliche Basis für Stabilität und Bindung.
L-Glutamin ist eine semi-essentielle Aminosäure und gehört zu den bedeutendsten Aminosäuren im menschlichen Stoffwechsel. Sie ist ein zentraler Baustein vieler Proteine.
Gewonnen aus den Samen der Guarbohne. Bekannt für seine klebrige, verdickende Konsistenz, die bereits in geringen Mengen Flüssigkeit bindet und zähflüssig macht.
Vollende deinen
Cycle of Intimacy®
Cycle of Intimacy®
Jede Phase der Intimität verdient die richtige Unterstützung. Kombiniere unsere Booster für ein ganzheitliches Gefühl von guter Vorbereitung, Genuss und Sicherheit.

Rezensionen aus Darstellungsgründen gekürzt. Alle Bewertungen hier.
Deine Fragen,
unsere Antworten
unsere Antworten
-
Die enthaltenen Quell- und Bindestoffe – darunter Psyllium und Glucomannan – binden Flüssigkeit und bilden im Darm ein Gel. Dieses unterstützt eine geformte, kompakte Ausscheidung. Viele empfinden ihren Toilettengang dadurch als vollständiger und angenehmer – für ein sauberes und sicheres Gefühl in intimen Momenten.
-
Die Kapseln sollten immer mit einem großen Glas Wasser eingenommen werden. Nur so können die enthaltenen Fasern ihr Volumen vollständig entfalten.
-
Die passende Dosierung kann individuell variieren – zum Beispiel je nach Gewicht, Ernährung oder persönlichem Empfinden. Unsere Empfehlung bietet dir einen sinnvollen Einstiegspunkt. Höre auf dein Körpergefühl und passe die Menge bei Bedarf an. Für noch mehr Orientierung kannst du unsere KI-Analyse nutzen – sie bezieht persönliche Faktoren mit ein und hilft dir, deinen Sweet Spot zu finden.
-
Ja. Die Get Ready Drops eignen sich unabhängig vom Geschlecht. Entscheidend ist die individuelle Dosierung. Menschen mit kleinerem bzw. leichterem Körperbau sollten mit einer niedrigeren Menge starten und diese nach Bedarf anpassen.
-
Wenn du regelmäßig Medikamente einnimmst, empfehlen wir, einen zeitlichen Abstand von etwa zwei Stunden einzuhalten. So wird vermieden, dass die Quellstoffe die Aufnahme deiner Medikamente beeinflussen. Bei Unsicherheiten sprich bitte mit deinem Arzt oder Apotheker – unsere Empfehlung ersetzt keine medizinische Beratung.














